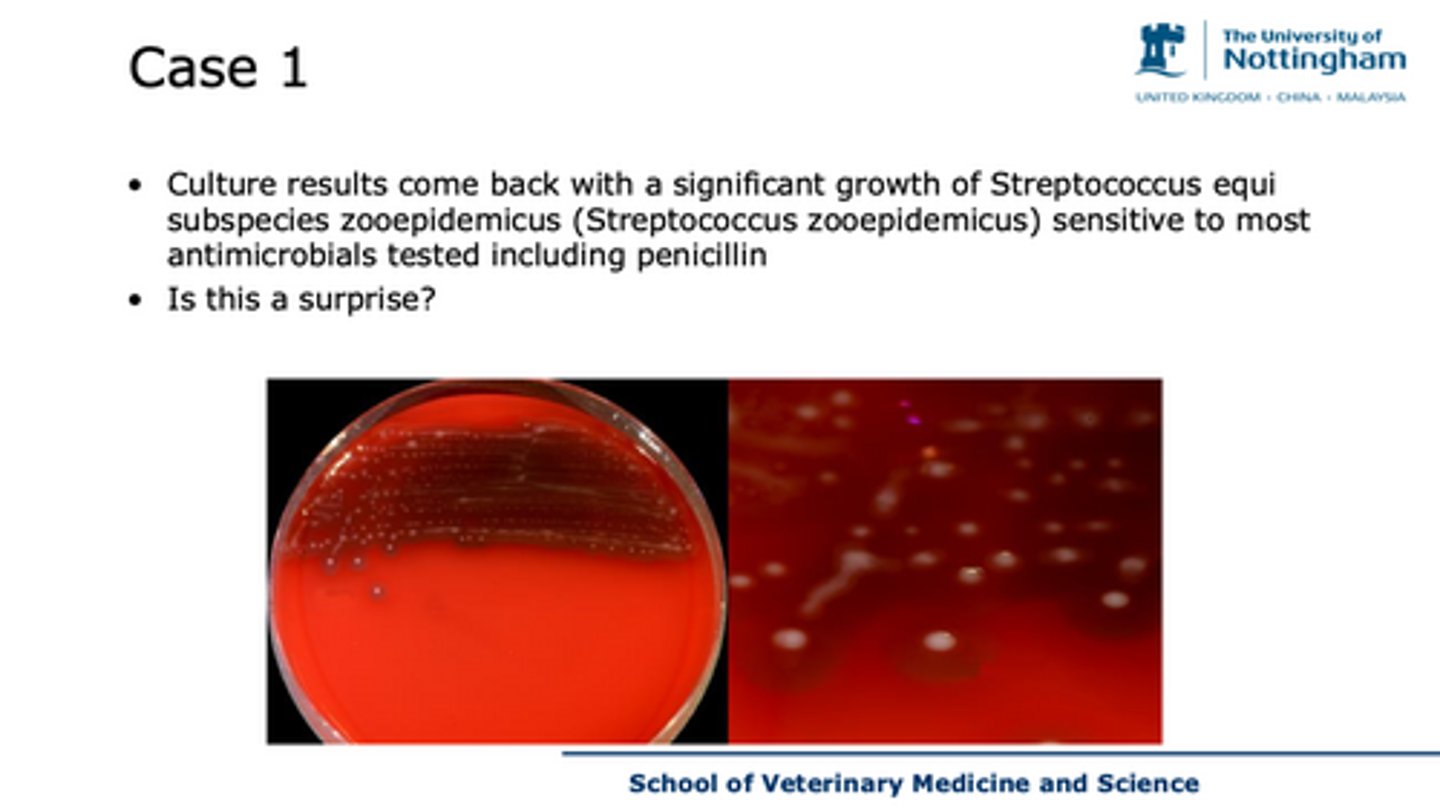
<p>case 1 - discuss the results of this culture</p>

infertility in all species: workshop
1/40
There's no tags or description
Looks like no tags are added yet.
Name | Mastery | Learn | Test | Matching | Spaced | Call with Kai |
|---|
No analytics yet
Send a link to your students to track their progress
41 Terms

case 1 - what does this image suggest, what stage does her behaviour suggest she's in
conformation - sunken anus, sloped
in early luteal phase
how long does oestrus last in horses?
3-6 days
can be variable
how long is the fertilisation period in a horse?
12 hours
when should mares be bred ?
before they ovulate, so sperm is in the tract ready for the ovum
when do we screen for bacterial venereal pathogens and why
cause endometritis
Screen at beginning of breeding season
So if we diagnose endometritis we know its not one of these 3
Stallions screened too
what is teasing
Stallion in environment where can show behaviour response but not get to
If mare responds likely in oestrus

case 1 - what can you see on this ultrasound
- uterus - thickened, inflammed, fluid filled (largely anechoic, some epigenic material),
- ovary - corpus haemorrhagicum and follicles

case 1 discuss this cytology?
segmented neutrophils - count amount in field in medial lens to see if its a normal amount for post mating - <5 normal - hugely inaccurate
lymphocytes
epithelial cells
endometritis - contamination of the uterus
unlikely to stay preg
how can we prevent bacterial contam in mares when there are conformation issues with the anus and vulva
Surgically adjust the contamination
Closes the dorsal commisure of vulva
Regually check the mare -> clean if soiled
incrs bcs if needed
what is the most common cause of infertility in the mare
post breeding endometritis
case 1 - discuss the results of this culture
commensal→ opportunistic pathogen
how might endomitritis affect the mares fertility?
may affect the mares ability to stay pregnant
case 1 how would you treat endometeritis ?
cause uterine contractions - oxytocin
lavage the uterus - remove particulate material
local antibiotics - into the uterus

case 2 - what is normal/ abnormal about asia's cyclicity
normal cyclicity
mating her too early - before the end of oestrus
how is dog ovulation different
Ovulates immature oocyte and takes few days to develop before can be fertilised
Stay in repro tract for couple days

case 2
what tests will you request ?
take a vaginal smear for cytology
request progesterone test

case 2
which antibiotic will you prescribe?
what cells are present?
what information does this give you?
- none
- nucleated cells - small intermediated nucleated epithelial cells, RBCs, neutrophil
Not in fertile period -> irrgulary shaped anucelar cells
So is too early in oestrus
- this tell us that she is not ready to mate -

case 2 what is the progesterone value ? and what does this mean with respect to time to breed ?
low progesterone value - rise occurs before ovulation and continues afterwards
retest in 2-4 days
don't advise breeding

case 2
progesterone now high enough

case 2 - what does this cause?
day of ovulation is variable
common is d12
and so are the signs
what is the fertilisation period like in dogs
Want to breed few d after ovulation
Fertilisation period in dog is 2 d after ovulation
Breeding too early means sperm has to survive until few d after ovulation
what is the fertile period
when mating could result in pregnancy


case 3 - which bits of history are important and why?
average 45L - High for herd
not observed signs of oestrus
she's beyond the kpi for the herd
so economic cost for farmer
the average of 11,000 is high for a 305 day
when do we want cows to be back in calve after calving
90d
what is voluntary wait period
Voluntary wait period= when an animal comes into oestrus but don’t ai for management reason, probs bc in peak lactation
42 d avg
what are the big 3 diseases in diary cattle
lameness
mastitis
fertility
how long is dry period
Dry period is 40-60d break before calving

case 3 - what are we going to do next?
clinical exam
rectal exam
scan her ovaries and uterus (pregnancy) -
vaginal mucous exam
- dry tacky - progesterone
- mucoid - oestrogen activity

case 3 - what is your diagnosis
small ovaries, small follicles, no dominant structures
So she is anoestrus so not cyclic -> is not ovulating

case 3 - what do we do next
there is a structure on L ovary which could be a CL→ check in 7 days
give progesterone implant to mimic luteal phase
five ovsynct - if you think there could be a CL

case 4 - whats your diagnosis?
pus in endometrium→ bc is not anechoic
endometritis
when do we see endometritis and metritis
endometritis= what we see in this stage in milk)
Metritis -> inflam of all 3 layers = what we see after calving

case 4 - how is this classified
severity - signs of health, clear discharge
grade 1 - abnormally enlarged uterus + prurulent discharge - without any systemic signs of ill health
grade 2 - additional signs of systemic illness - decreased milk yield, dullness, fever
grade 3 - poor prognosis - animals with signs of toxaemia - inappetance, cold extremities, depression and or collapse, thick white and smelly discharge

case 4 how do you treat?
antibiotics - intrauterine - scoring 3 or more
give prostaglandins - causes contractions of myometrium, removes CL, oestrogens would help clear discharge

case 4 what are risk factors for this?
- retained foetal membranes
- dystocia
- uterine inertia - hypoglycaemia, negative energy balance

case 5 - what is your presumptive diagnosis ? and why ?
follicular cyst 30 mm roughly
abnormal large structure
presumptive bc cyst needs to be therefor 7 days and more than 2.5 cm
so this is a guess from a one off visit
pedometer and nymphomania - suggest oestrus (18-24 hours)
however has been longer
there is also a follicle
Is more active than the cyst bc has a strong wall and is more robust
So cyst might not eb functional
But cant tell for fact is an assumption

case 5 - how do we treat this?
do nothing - might be non-dominant, will take weeks to disappear
OR
give ovsync - GNRH - luteinises structures, second dose of prostaglandin to remove CL, this would restart normal cycle.
or use PRID device to mimic luteal phase
nymphomania
hypersexuality
excessive sexual behaviour

case 6 - why do we measure testes size ?
Larger testes → Higher sperm count & motility.

case 6 - what impacts testicular size?
>Age
>nutrition
>seasonality (sheep are seasonal breeders so testes are smaller outside of season)
>Health status

case 6 - what are the 5 Ts of rams breeding soundness exam
>Testes – Size, symmetry, firmness.
>Teeth – Good dentition for adequate nutrition.
>Toes – Hoof health to ensure mobility.
>Tone – Body condition score (BCS) 3-3.5.
>Tossle (Penis) – Check for lesions, infection, or injuries.